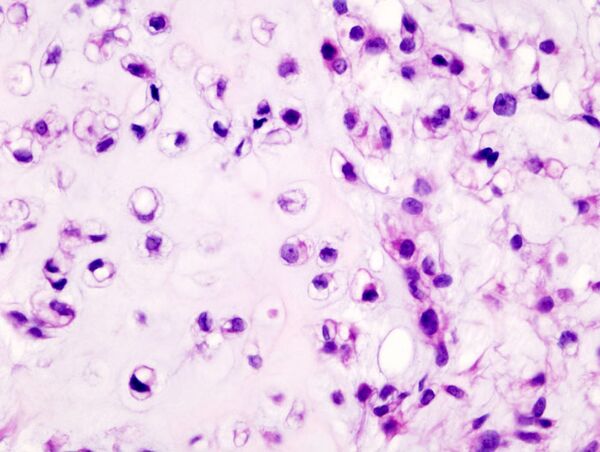

Хондросаркома
Хондросаркóма — злокачественная опухоль кости. Наблюдается преимущественно в среднем и пожилом возрасте, причём у мужчин в два раза чаще, чем у женщин.
Может возникать в любой кости (будь то длинная трубчатая, плоская или короткая), развивающаяся из хряща путём энхондрального окостенения. Чаще локализуется в костях таза, плечевого пояса и ребрах, реже в конечностях и позвоночнике. Нередко поражает проксимальные концы бедренной и плечевой кости.
У 10-15 % больных хондросаркомы развиваются вторично из предшествующих патологических процессов: остеохондроматоз, энхондромы, экхондромы, солитарные остеохондромы, болезнь Олье (дисхондроплазия), болезнь Пэджета (деформирующая остеодистрофия)[2].
Общие сведения
Классификация
Хондросаркомы могут возникать первично (de novo), или вторично в существующем хрящевом образовании[3].
Термин «хондросаркома» используется для обозначения гетерогенной группы опухолей с различными морфологическими свойствами и клиническими проявлениями. В зависимости от происхождения хондросаркомы делятся на первичные и вторичные, а в соответствии с локализацией в поражённой кости — на центральные (костномозговые) и периферические (поверхностные) формы[4].
- интрамедуллярная хондросаркома (первичная центральная хондросаркома)
- юкстокортикальная хондросаркома
- светлоклеточная хондросаркома
- миксоидная хондросаркома
- мезенхимальная хондросаркома
- внескелетная хондросаркома
- дедифферинцированная хондросаркома
- из остеохондромы
- солитарная остеохондрома
- наследственные множественные экзостозы
- из энхондромы
- солитарная энхондрома
- болезнь Олье
- синдром Маффучи
Этиология
Точные причины первичной хондросаркомы до сих пор неясны и неизвестны.
- Сильные бедренные боли (в результате сдавления опухолью седалищного нерва), боли в спине и крестце, реже в позвоночнике, которые усиливаются по мере роста опухоли.
- Затруднения движения суставов, сопровождающихся сильной болью.
- Частая отечность над местом локализации опухоли.
- Пояснично-крестцовый радикулит.
Клиника и диагностика
Основным признаком озлокачествления хондромы является внезапное увеличение размеров ранее существовавшей доброкачественной опухоли. Клиническое течение хондросарком обычно медленное. Опухоль постепенно распространяется по длиннику (диафизу) кости. Инфильтрация, прорастание и разрушение коркового слоя кости опухолью происходит медленно При прорыве опухоли через надкостницу в мягкие ткани её рост обычно ускоряется. Быстро текущие формы хондросарком наблюдается примерно у 10 % больных.
Характерным является гематогенное метастазирование в лёгкие, которое наблюдается значительно реже и позже, чем при остеосаркомах. Местные рецидивы часты и более злокачественны, чем первичные опухоли.
Ведущим методом распознавания хондросарком является рентгенологическое исследование.
- Рентгенологическими признаками озлокачествления опухоли хрящевой ткани являются быстрое нарастание деструкции, разрушение кортикального слоя, которое может наблюдаться на небольшом участке, выхода опухоли в прилежащие к кости мягкие ткани. Периостальные наслоения в виде козырька или спикул выражены нерезко.
Хондросаркома разделяется на:
Патологическая анатомия
Хондросаркома — злокачественная опухоль хрящевого строения. Хондросаркома периферической локализации хорошо выявляется в виде плотной опухоли, прилегающей к кортикальному слою кости, иногда прорастающей в кость на различную глубину. В ней могут быть очаги оссификации и петрификаты. Опухоль плотноэластической консистенции, при наличии ослизнения, распада или кровоизлияний — более мягкая, не имеет ясного ограничения от соседней ткани. При разрезе нетрудно определить хрящевой её характер. При микроскопическом исследовании опухоль напоминает иногда хондрому, состоит из незрелых клеток с резко выраженным клеточным атипизмом. Часто рисунок опухоли имеет вид микросаркомы, в которой можно найти участки хрящевой ткани с плохо оформленными ячейками, содержащие неправильной формы хондробласты.
Лечение
- Оперативное вмешательство — включает в себя полное иссечение первичной опухоли вместе с метастазами. Нередко приходится делать ампутации и экзартикуляции конечности с половиной таза или плечевым поясом.
- Лучевая терапия — подходит только для ранних стадий хондросарком, так как в более поздних стадиях опухоли устойчивы к радиоизлучению.
- Химиотерапия — подходит для высокодифференцированной и мезенхимной хондросаркомы, которые очень чувствительны к химиотерапевтическим препаратам.
- Комплексные терапии включают в себя наиболее эффективные методы лечения при всех типах хондросарком — радиохирургическое либо химиохирургическое лечение.
Прогноз
Прогноз у больных хондросаркомами после радикального радиохирургического лечения значительно лучше, чем у больных остеосаркомами. После оперативного лечения 5 лет и более живут 17-25 % больных.
Фотографии
Примечания
Литература
- Онкология — учебник для мед. ин-тов / Б. Е. Петерсон. — М.: Медицина, 1980. — 447 с.: ил. — 01.20 р.
- Общая онкология / Под ред. Н. П. Напалкова.— Л., 1989.
- Справочник по онкологии /Под ред. акад. РАМН Н. Н. Трапезникова и проф. И. В. Поддубной. М., 1996.